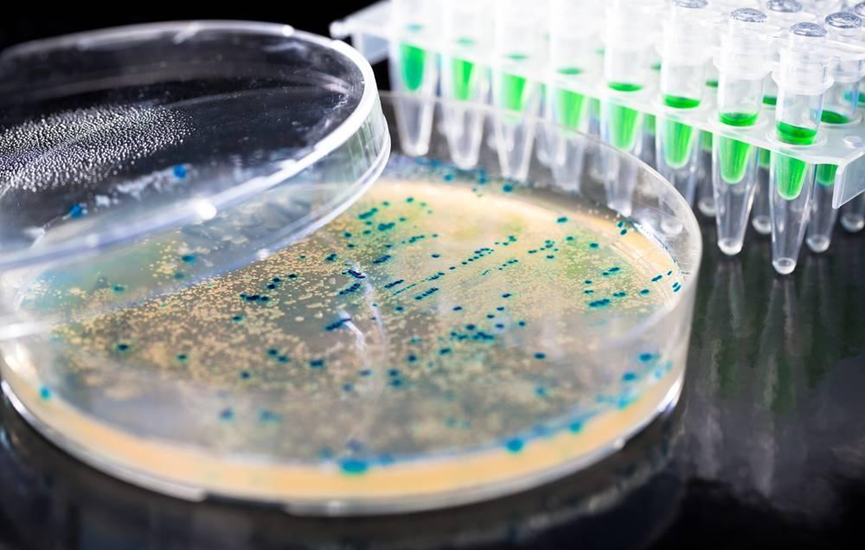

载体构建
技术简介
载体(vector construction),为把DNA分子运送到受体细胞中去,必须寻找一种能进入细胞、且装载了外来的DNA片段后仍能照样复制的载体。理想的载体是质粒(plasmid),在基因工程中,常用人工构建的质粒作为载体。载体构建即是构建含外源DNA的质粒。
载体构建((vector construction),载体是整个基因工程的基石,是DNA重组技术的核心要素。为了满足研究的需要,我们需要按照自己的意愿有目的的去构建和改造载体,最终实现扩增目标片段或者特定蛋白表达等目的。
服务内容
| 服务项目 | 分类 |
| 目的片段克隆 | 目的基因片段插入特定载体多克隆位点上,可按客户要求融合表达不同的报告基因、蛋白标签等 |
| 载体元件改造 | 多克隆位点改造,启动子、增强子、筛选标记等功能元件的改造 |
常见服务
| 载体种类 | 载体类型 | 周期 |
| 原核表达载体 | 蛋白纯化pET系列;pGEX-4T-1;等 双元启动子载体 | 10~15天 |
| 真核表达载体 | pCDNA3.1;pEGFP-N1;pEGFP-C1; pDsRed-Monomer-N1等 | 10~15天 |
| 启动子活性检测载体 | pGL3-BASIC;pGL4.17等 | 10~15天 |
| 植物表达/干扰载体 | pCAMBIA系列;等 | 20~25天 |
| 酵母表达载体 | pPIC9k; pYES2等 | 10~15天 |
| 慢病毒载体 | 慢病毒基因表达载体pCDH-Puro; pCDH-GFP-Puro; 慢病毒干扰载体pLKO.1 | 20~25天 |
| 腺病毒及腺相关载体 |
|
|
| CRISPR/Cas9系统载体 |
|
|
注:我司现有载体库几乎覆盖实验室常用的各类载体,可为客户免费提供;也可完成客户提供载体的构建服务。
技术优势
虽然载体构建是分子生物学研究中最常用的技术之一,但由于构建目的的多样性,加之实际操作中影响因素较多,对研究者经验要求较高,因而往往费时费力。
本公司拥有长期从事分子生物学工作的丰富经验,集中人力,为您提供高效、快捷的载体构建服务。我们可根据已有载体进行改造方案的设计,完成现有载体不同功能元件的改造,也可以应客户要求将指定片段亚克隆至各种载体。
服务流程(图)
基因全合成或基因克隆(此技术服务可选,客户只需提供基因序列或组织材料即可)——序列审核、引物设计——目的基因片段与载体连接——阳性克隆筛选——测序验证
您需要提供的材料
1. 实验材料与相关资料
普通载体构建改造:载体、PCR或者酶切产物、载体图谱、载体来源信息与基因背景资料;
表达载体、报告基因载体、病毒载体:载体、含目的基因的质粒或cDNA模板、载体图谱与序列信息、目标蛋白基因序列与酶切位点信息。
2. 载体构建与改造方案
注:
1. 请确认待改造的载体序列正确,与提供的图谱等信息匹配,构建完成后如需测序并且要求序列完全匹配,则需要您提供全序列信息;
2. 如果您只提供组织或细胞样本,请提供所需克隆基因的NCBI登录号或电子版全序列,并额外收取RNA提取及逆转录的费用;
3.对于本公司已有的载体和模板,我们可以免费提供,详见 载体库。
您将获得以下实验结果
1.实验报告:包括序列信息、测序引物、所用酶切位点信息等;
2.测序结果:测序彩色波形图、测序方向图、序列碱基图;
3.构建好的重组质粒(100ng/μL,20μL)及相应的甘油保存菌(1mL)。
实验结果图片示例:
